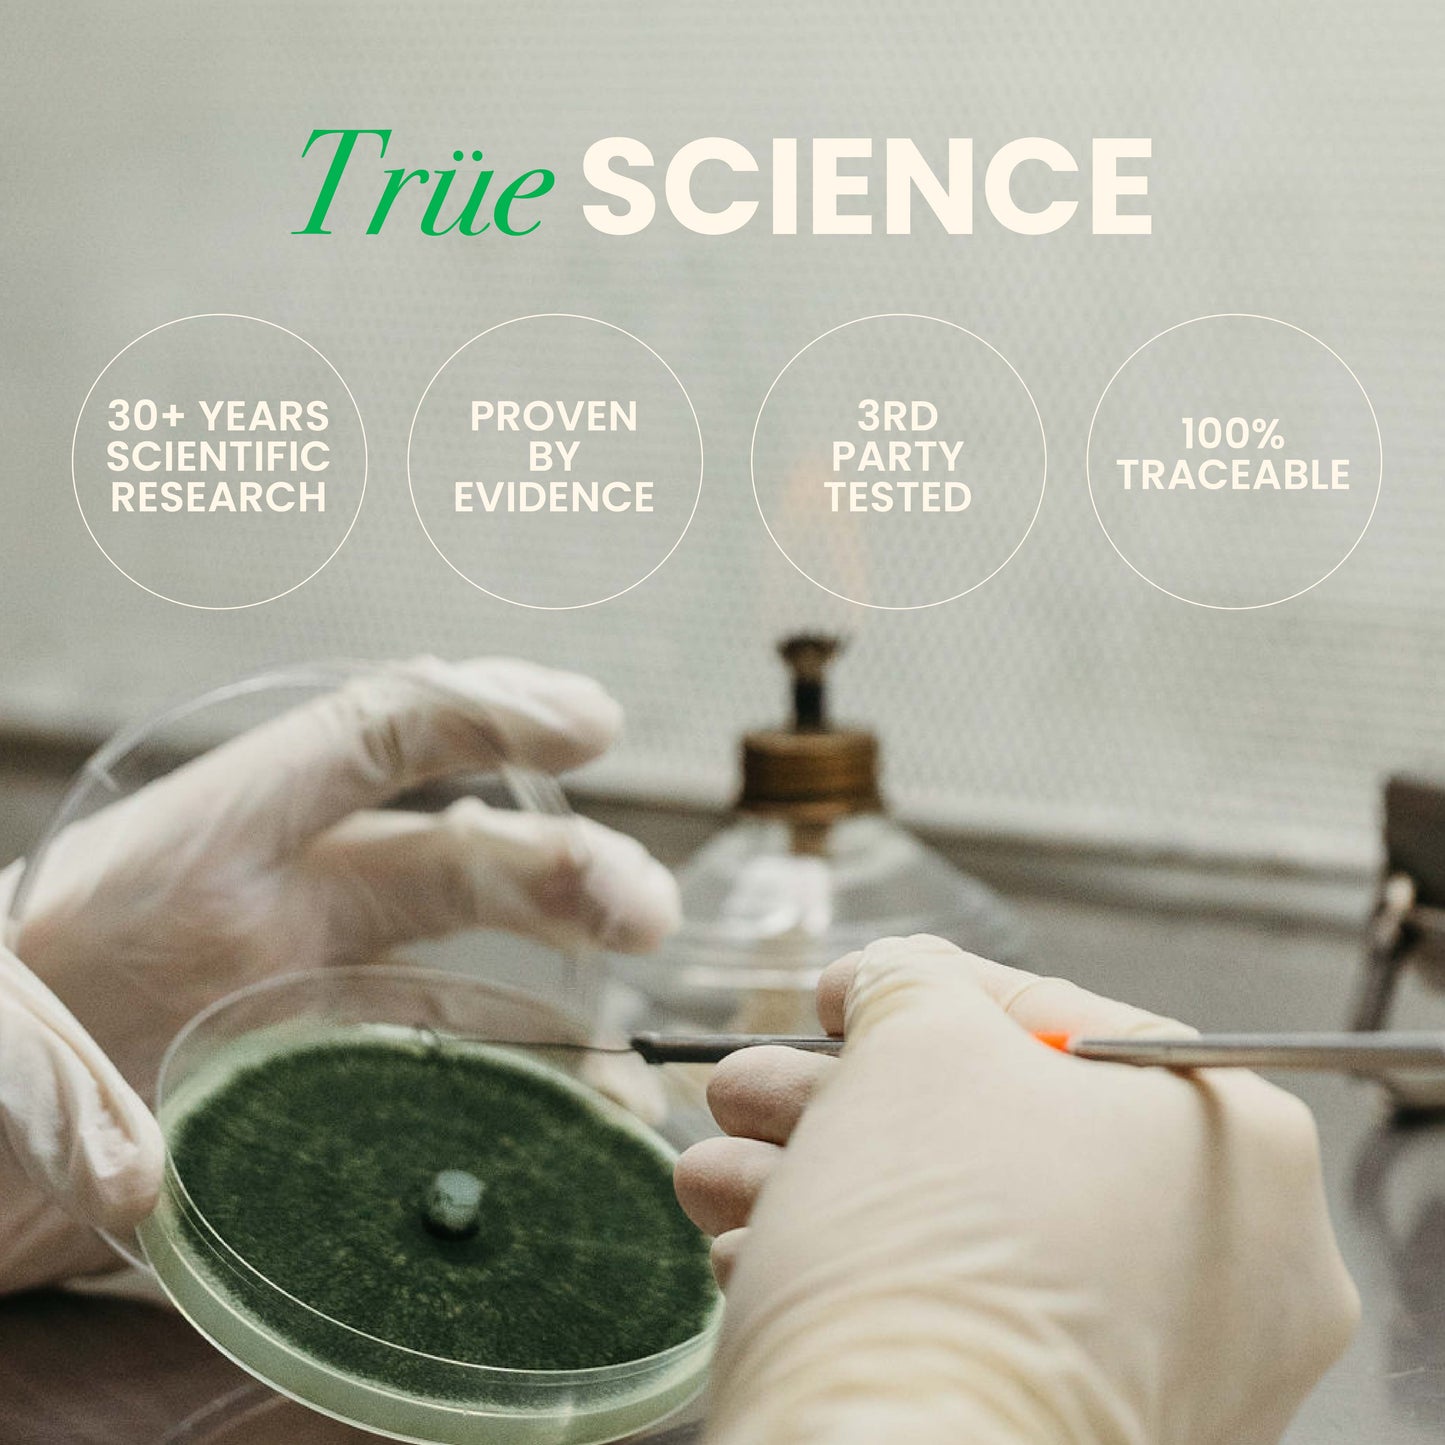

Acemannan Aloe Vera Capsules
almä is a True Acemannan supplement, aloe vera’s most powerful compound for gut, immune, and healthy aging support. Purity verified in every batch and preserved bioidentical to the plant.
Inner-leaf gel aloe vera capsules. Proven lab results. Real balance from the inside out.
✔ Free shipping & 30-Day money-back guarantee. Limited time!
✔ Subscribe and save $10
✔ 7× Active potency vs. standard aloe. Replace 17+ supplements.
✔ Third-party verified + every batch tested for purity.
✔ 30+ years of science-backed results. NSF & FDA certified.
For a deeper breakdown of the research and molecular standards, see our Acemannan Science Library
Monthly Subscription SAVE $10
2 Bottles* / $10 OFF at checkout
3 Bottles* / $25 OFF at checkout - Best Value!
Real purity creates real results. Our customers report calm digestion, radiant skin, and balanced energy, all tested by third-party university labs.
- Preserved actives: Not just True Acemannan, but LM pectin + essential sugars (the trio your body can’t get anywhere else). Preserved by our proprietary cold extraction technique.
- Concentrated growth: One full year of leaf growth, concentrated into just two capsules, delivering the plant’s full potential.
- Batch testing: Verifying every single batch for purity and potency. Others guess, we test.
- Third party verified: by independent university labs.
Real purity creates real results. Our customers report calm digestion, radiant skin, and balanced energy, all tested by third-party university labs.
- Preserved actives: Not just True Acemannan, but LM pectin + essential sugars (the trio your body can’t get anywhere else). Preserved by our proprietary cold extraction technique.
- Concentrated growth: One full year of leaf growth, concentrated into just two capsules, delivering the plant’s full potential.
- Batch testing: Verifying every single batch for purity and potency. Others guess, we test.
- Third party verified: by independent university labs.
Gut health: Ease bloating and support balance with natural pre, pro, and post-biotic action.
Immunity: Supports balance and regulation in your body, helping it know when to fight and when to rest.
Aging Support: Calm inflammation, protect cells from oxidative stress, enhance cell-to-cell communication to keep energy and vitality on your side.
Gut health: Ease bloating and support balance with natural pre, pro, and post-biotic action.
Immunity: Supports balance and regulation in your body, helping it know when to fight and when to rest.
Aging Support: Calm inflammation, protect cells from oxidative stress, enhance cell-to-cell communication to keep energy and vitality on your side.
Acemannan Aloe Vera Capsules
almä is a True Acemannan supplement, aloe vera’s most powerful compound for gut, immune, and healthy aging support. Purity verified in every batch and preserved bioidentical to the plant.
Inner-leaf gel aloe vera capsules. Proven lab results. Real balance from the inside out.
✔ Free shipping & 30-Day money-back guarantee. Limited time!
✔ Subscribe and save $10
✔ 7× Active potency vs. standard aloe. Replace 17+ supplements.
✔ Third-party verified + every batch tested for purity.
✔ 30+ years of science-backed results. NSF & FDA certified.
For a deeper breakdown of the research and molecular standards, see our Acemannan Science Library
Monthly Subscription SAVE $10
2 Bottles* / $10 OFF at checkout
3 Bottles* / $25 OFF at checkout - Best Value!
Real purity creates real results. Our customers report calm digestion, radiant skin, and balanced energy, all tested by third-party university labs.
- Preserved actives: Not just True Acemannan, but LM pectin + essential sugars (the trio your body can’t get anywhere else). Preserved by our proprietary cold extraction technique.
- Concentrated growth: One full year of leaf growth, concentrated into just two capsules, delivering the plant’s full potential.
- Batch testing: Verifying every single batch for purity and potency. Others guess, we test.
- Third party verified: by independent university labs.
Real purity creates real results. Our customers report calm digestion, radiant skin, and balanced energy, all tested by third-party university labs.
- Preserved actives: Not just True Acemannan, but LM pectin + essential sugars (the trio your body can’t get anywhere else). Preserved by our proprietary cold extraction technique.
- Concentrated growth: One full year of leaf growth, concentrated into just two capsules, delivering the plant’s full potential.
- Batch testing: Verifying every single batch for purity and potency. Others guess, we test.
- Third party verified: by independent university labs.
Gut health: Ease bloating and support balance with natural pre, pro, and post-biotic action.
Immunity: Supports balance and regulation in your body, helping it know when to fight and when to rest.
Aging Support: Calm inflammation, protect cells from oxidative stress, enhance cell-to-cell communication to keep energy and vitality on your side.
Gut health: Ease bloating and support balance with natural pre, pro, and post-biotic action.
Immunity: Supports balance and regulation in your body, helping it know when to fight and when to rest.
Aging Support: Calm inflammation, protect cells from oxidative stress, enhance cell-to-cell communication to keep energy and vitality on your side.
Expert Reviews
See what health practitioners and experts are saying about almä.
Let customers speak for us
Backed by 30 Years of Research
Our proprietary process locks in aloe's fragile compounds (true acemannan, LM pectin, and essential sugars) that most products lose. These are the very molecules responsible for gut, immune, and skin benefits.

Our process was built on decades of aloe research, perfected in the field.
Hand-harvested and processed within hours, preventing enzymatic breakdown.
Third-party university labs confirm higher levels of bioactives compared to standard supplements.
Natural aloin safely drained and returned to the soil as fertilizer.
No fillers, no pesticides, no shortcuts. Every capsule contains aloe vera's key compounds in its most biologically active form.
Each serving delivers the concentrated power of a full plant, not a fraction.
Backed by 30 Years of Research
Our proprietary process locks in aloe's fragile compounds (true acemannan, LM pectin, and essential sugars) that most products lose. These are the very molecules responsible for gut, immune, and skin benefits.
Our process was built on decades of aloe research, perfected in the field.
Hand-harvested and processed within hours, preventing enzymatic breakdown.
Third-party university labs confirm higher levels of bioactives compared to standard supplements.
Natural aloin safely drained and returned to the soil as fertilizer.
No fillers, no pesticides, no shortcuts. Every capsule contains aloe vera's key compounds in its most biologically active form.
Each serving delivers the concentrated power of a full plant, not a fraction.

Backed by 30 Years of Research
Our proprietary process locks in aloe's fragile compounds (true acemannan, LM pectin, and essential sugars) that most products lose. These are the very molecules responsible for gut, immune, and skin benefits.
Our process was built on decades of aloe research, perfected in the field.
Hand-harvested and processed within hours, preventing enzymatic breakdown.
Third-party university labs confirm higher levels of bioactives compared to standard supplements.
Natural aloin safely drained and returned to the soil as fertilizer.
No fillers, no pesticides, no shortcuts. Every capsule contains aloe vera's key compounds in its most biologically active form.
Each serving delivers the concentrated power of a full plant, not a fraction.

The Trio

True Acemannan
Proven to support inflammation, healthy aging, and immune balance.

LM Pectin
Supports the gut lining and may help repair damaged tissue.

Essential Sugars
Fuel cellular communication and support immune balance.

Full Spectrum Benefits
Results you’d normally need multiple supplements to even attempt.
Lab Testing Standards
Most supplements do one quick test. At almä, every batch is fully analyzed to guarantee purity, potency, and authenticity.
- 24/7 HPLC testing for acemannan and aloin removal
- FTIR authentication to confirm real, unadulterated aloe
- Microbiology + sterility checks on product, equipment, and air
- NSF-certified facility standards rare in the supplement industry
- Independent U.S. lab verification for every key marker
Every bottle is batch-tested, and your exact batch results are available in the product gallery.

Lab Testing Standards
Most supplements do one quick test. At almä, every batch is fully analyzed to guarantee purity, potency, and authenticity.
We go further with:
- 24/7 HPLC testing for acemannan and aloin removal
- FTIR authentication to confirm real, unadulterated aloe
- Microbiology + sterility checks on product, equipment, and air
- NSF-certified facility standards rare in the supplement industry
- Independent U.S. lab verification for every key marker
Every bottle is batch-tested, and your exact batch results are available in the product gallery.

Lab Testing Standards
Most supplements do one quick test. At almä, every batch is fully analyzed to guarantee purity, potency, and authenticity.
We go further with:
- 24/7 HPLC testing for acemannan and aloin removal
- FTIR authentication to confirm real, unadulterated aloe
- Microbiology + sterility checks on product, equipment, and air
- NSF-certified facility standards rare in the supplement industry
- Independent U.S. lab verification for every key marker
Every bottle is batch-tested, and your exact batch results are available in the product gallery.

Process and Impact
Where it’s grown, how it’s made, and why it works.

Frequently Asked Questions

True Acemannan is the most potent compound in inner leaf aloe vera, responsible for the gut-healing, immune-supporting, and anti-inflammatory effects mentioned in scientific studies. Most brands destroy this fragile compound during heat processing, but almä’s low-heat, freeze-dried method preserves it in full strength.
almä is ideal for people experiencing digestive discomfort, inconsistent bowel habits, bloating, low immunity, chronic inflammation, or anyone wanting a clean, plant-based daily wellness ritual that supports long-term gut and immune balance. Always speak to your doctor before trying a new supplement.
Short-term improvements often appear within a couple of weeks, but for deeper changes in gut integrity, inflammation balance, and immune function, it is best to evaluate your progress after twelve weeks of daily use.
almä uses aloe grown in Costa Rica in nutrient-rich volcanic soil. The inner leaf gel is harvested carefully, the outer rind and bitter latex are removed, and the extract is stabilized through low-heat freeze-drying to protect delicate polysaccharides like True Acemannan.
Each bottle contains the concentrated equivalent of 30 whole aloe vera leaves, with an industry-leading 500mg per serving. This delivers a therapeutic dose in just two capsules a day, no bulky drinks or diluted juices required.
No. almä is made only from the inner gel, avoiding the harsh compounds found in whole-leaf or outer-rind aloe vera products. The aloin is manually drained from every plant in processing.
Please consult with your healthcare provider before using any supplement during pregnancy or breastfeeding.
almä is corn-free, soy-free, gluten-free, and free from preservatives and fillers. It's non-GMO and vegan.
almä uses only the gel from the inner leaves. The outer leaves are trimmed away and the gel is collected for further refinement. Click to learn more about almä’s proprietary Farm-To-Capsule process.
Take two capsules once per day (ideally on an empty stomach or between meals), and use consistently for several weeks to allow gut and immune benefits to develop fully.
Yes, if you are sensitive or coming off a period of digestive imbalance, you may start with one capsule daily for five to seven days and then increase to the full two-capsule serving once you feel comfortable.
Yes, you can open the capsules and mix the powder into water, juice, or a smoothie. The taste is mild and blends easily.
almä can generally be taken alongside most daily routines. If you take specific medications or follow a supplement regimen, speak with a practitioner to personalize your timing.
Simply resume your regular dose the next day. There is no need to double up.
All orders placed before 3 PM EST ship the same day. Orders received after that time ship the following business day. You’ll receive a tracking number by email as soon as your package leaves our facility.
Standard U.S. shipping typically takes 3–5 business days. Expedited options are available at checkout. International delivery times vary depending on customs and location.
Yes. We guarantee your order will reach you safely. If your package is lost, damaged, or misdelivered by the carrier, we’ll replace it (no questions asked).
We offer a 30-day money-back guarantee on all almä products. If you’re not completely satisfied, simply email support@almadaily.com or DM us on Instagram (@dailyalma) within 30 days of delivery. We’ll issue a full refund once your return is received.
Absolutely. Every almä batch undergoes full third-party testing to confirm compound consistency, including active acemannan levels, LM-pectin integrity, and microbiological purity. This ensures every capsule delivers the same verified profile found in our lab results.
Please contact us right away at support@almadaily.com or DM @dailyalma. We’ll investigate and make sure a replacement reaches you promptly.
If your order hasn’t shipped yet, we’ll gladly update or cancel it. Reach out immediately via email or DM so we can catch it before it leaves our facility.
Yes, we ship worldwide. Shipping times and customs fees vary depending on your country. Any applicable import duties are the customer’s responsibility.
Email support@almadaily.com or DM us on Instagram (@dailyalma). Our support team is available Monday–Friday, 9 AM–6 PM EST, and typically replies within 24 hours.
Yes, absolutely. There are no commitments or hidden fees. You can cancel or modify your subscription anytime through your account dashboard.
- When you subscribe, you are locked in to 2 payments
Just login into your account page and you’ll find a “Manage my subscription” link in the main menu: https://account.almadaily.com